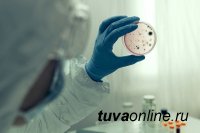

|
|
|
|
|
|
|
|
11 августа 2020 г. | Просмотров: 5469 | Комментариев: 0 |
|
|
 За последние сутки выписан 161 пациент, в том числе после подтверждения диагноза методом лабораторного тестирования – 136. За последние сутки выписан 161 пациент, в том числе после подтверждения диагноза методом лабораторного тестирования – 136.
За весь период выздоровело 5188 больных с лабораторно-подтвержденным диагнозом. Коэффициент распространения инфекции составил 0,9.
|
|
|
|
|
|
|
|
|
|
|
|
|
11 августа 2020 г. | Просмотров: 2483 | Комментариев: 0 |
|
|
Сотрудники управления Роспотребнадзора по республике Тува выявили распространение возбудителя чумы в природных очагах в Овюрском и Монгун-Тайгинском кожуунах региона. Об этом говорится в сообщении на сайте ведомства. Сотрудники управления Роспотребнадзора по республике Тува выявили распространение возбудителя чумы в природных очагах в Овюрском и Монгун-Тайгинском кожуунах региона. Об этом говорится в сообщении на сайте ведомства.
|
|
|
|
|
|
|
|
|
|
|
|
|
11 августа 2020 г. | Просмотров: 5154 | Комментариев: 0 |
|
|
 Площадка для сдачи норм ГТО – это настоящий тренажерный зал под отрытым небом. Любители спорта уже активно осваивают тренажеры. На стадионе всегда многолюдно, каждый день и взрослые, и дети приходят сюда заниматься спортом. Площадка для сдачи норм ГТО – это настоящий тренажерный зал под отрытым небом. Любители спорта уже активно осваивают тренажеры. На стадионе всегда многолюдно, каждый день и взрослые, и дети приходят сюда заниматься спортом.
Председатель администрации сумона Сукпак Сергей Решетников поблагодарил всех, кто активно помогал в постройке площадки.
|
|
|
|
|
|
|
|
|
|
|
|
|
11 августа 2020 г. | Просмотров: 3078 | Комментариев: 0 |
|
|
 Два человека погибли на ж/д путях в районе станции Бикин в Хабаровском крае, сообщает «АиФ Дальинформ». Два человека погибли на ж/д путях в районе станции Бикин в Хабаровском крае, сообщает «АиФ Дальинформ».
«11 августа в 03:09 местного времени на 8762 км перегона "Бикин – Звеньевой" Дальневосточной железной дороги произошел групповой несчастный случай. Два человека сидели на рельсах перед идущим пассажирским поездом № 351 "Владивосток – Советская Гавань"
|
|
|
|
|
|
|
|
|
|
|
|
|
11 августа 2020 г. | Просмотров: 6641 | Комментариев: 0 |
|
|
 Министр здравоохранения Тувы 37-летний Артыш Сат относится к молодому призыву нынешнего состава правительства республики. Было интересно с ним побеседовать и лучше понять линию карьерного роста, внутреннюю мотивацию молодого управленца, поговорить о жестких уроках коронавируса. Министр здравоохранения Тувы 37-летний Артыш Сат относится к молодому призыву нынешнего состава правительства республики. Было интересно с ним побеседовать и лучше понять линию карьерного роста, внутреннюю мотивацию молодого управленца, поговорить о жестких уроках коронавируса.
– Артыш Михайлович, в чем для вас главная составляющая современного управленца?
– Это ответственность, конечно.
|
|
|
|
|
|
|
|
|
|
|
|
|
11 августа 2020 г. | Просмотров: 2155 | Комментариев: 0 |
|
|
 Минприроды Республики Тыва сообщает, о том, что с 1 августа 2020 года начался летне-осенний сезон охоты на кабана, за исключением самок с приплодом текущего года, сибирского горного козла, бурого медведя, а с 15 августа 2020 года на взрослых самцов сибирской косули, бурундука, барсука, норки (американской), хоря (степного). Минприроды Республики Тыва сообщает, о том, что с 1 августа 2020 года начался летне-осенний сезон охоты на кабана, за исключением самок с приплодом текущего года, сибирского горного козла, бурого медведя, а с 15 августа 2020 года на взрослых самцов сибирской косули, бурундука, барсука, норки (американской), хоря (степного).
|
|
|
|
|
|
|
|
|
|
|
|
|
11 августа 2020 г. | Просмотров: 2439 | Комментариев: 0 |
|
|
 СПК «Тараа», в лице Монгуш Розы Доржукаевны при поддержке ГАУ «Информационный центр туризма Республики Тыва» совместно с Департаментом по развитию туризма Министерства экономики Республики Тыва готовит к открытию чабанскую стоянку «Дус-Даг» в живописном месте недалеко от города Кызыл, рядом с минеральным источником Тос-Булак, с целью развития внутреннего и въездного туризма и увеличения туристского потока. СПК «Тараа», в лице Монгуш Розы Доржукаевны при поддержке ГАУ «Информационный центр туризма Республики Тыва» совместно с Департаментом по развитию туризма Министерства экономики Республики Тыва готовит к открытию чабанскую стоянку «Дус-Даг» в живописном месте недалеко от города Кызыл, рядом с минеральным источником Тос-Булак, с целью развития внутреннего и въездного туризма и увеличения туристского потока.
|
|
|
|
|
|
|
|
|
|
|
|
|
11 августа 2020 г. | Просмотров: 2114 | Комментариев: 0 |
|
|
 Прокуратура проведет проверку работы ГИБДД в Туве после увеличения количества крупных ДТП с большим количеством пострадавших и массовых нарушений правил дорожного движения, сообщает ИА «ТуваМедиаГрупп» Прокуратура проведет проверку работы ГИБДД в Туве после увеличения количества крупных ДТП с большим количеством пострадавших и массовых нарушений правил дорожного движения, сообщает ИА «ТуваМедиаГрупп»
На территории региона зарегистрировано более 200 дорожно-транспортных происшествий, в которых погибло 54 человека, в том числе 4 ребенка, травмировано свыше 360 человек.
|
|
|
|
|
|
|
|
|
|
|
|
|
11 августа 2020 г. | Просмотров: 2602 | Комментариев: 0 |
|
|
 В соответствии со Стратегией развития туризма в РФ на период до 2035 года Правительством Республики Тыва принята Концепция развития туризма в Республике Тыва до 2025 года. В соответствии со Стратегией развития туризма в РФ на период до 2035 года Правительством Республики Тыва принята Концепция развития туризма в Республике Тыва до 2025 года.
Реализация программы позволит создать необходимую обеспечивающую инфраструктуру, в полной мере использовать потенциал приграничного региона. Должны появиться условия для привлечения инвесторов.
|
|
|
|
|
|
|
|
|
|

| | | |
Анонс событий | 1) СЕГОДНЯ: Всемирный день окружающей среды (с 1973 г. по
решению Генеральной Ассамблеи ООН) |
2) СЕГОДНЯ: new! Публичные слушания по проекту закона Республики Тыва «Об исполнении республиканского бюджета Республики Тыва за 2025 год» Начало в 10 ч (Первый зал Дома правительства, Кызыл, Тува) |
3) ЗАВТРА: 75 лет (1951) со дня рождения Владимира Анатольевича Семенова, ученогоархеолога, кандидата исторических наук. (Санкт-Петербург-Тыва) |
4) ЗАВТРА: new! Круглый стол «Развитие экотуризма на особо охраняемых природных территориях Республики Тыва». Начало в 9 ч (Конференц-зал "Буян-Бадыргы", Кызыл, Тува) |
5) ЗАВТРА: new! Торжественное мероприятие, посвященное Дню социального работника. Начало в 15 ч (Центр культурного развития, Кызыл, Тува) |
6) ЗАВТРА: new! Проведение единого дня субботника, пресвященного Дню эколога. (Муниципалитеты Тувы, Кызыл, Тува) |
7) 06.06.2026: День русского языка в России (с 2011 г.) (Россия) |
8) 06.06.2026: new! Всероссийская общественная акция «Пушкинский диктант». Начало в 11 ч (Тувинский республиканский лицей-интернат, Кызыл, Тува) |
9) 08.06.2026: День социального работника (Россия) |
10) 10.06.2026: 60 лет (1966) со дня создания в г. Кызыле телевизионной студии (ныне Государственная телерадиокомпания «Тыва»). (Кызыл, Тува) | все даты |
| | | | |
|
